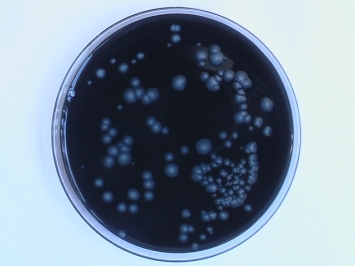
�쥸���ͥ�°��ʬ��

HOME >> 水質分析関連に関するコラム >> レジオネラ属菌分析
レジオネラ属菌分析
最近では、ホテル、温泉、老人ホーム等で問題になっているレジオネラ属菌は、本来環境細菌であり、湿った土壌、池や沼、湖、河川等の淡水に生息しています。人工的な環境の中で一番関わりが強いのがビルや工場等の空調用冷却塔水です。その他に、ため水、家庭や業務用(工場、病院等)の給湯器、修景用水(公園、噴水)、循環式浴槽(24時間風呂)、雑用水(トイレや車両の洗浄水)、シャワーの溜まり水、プール、温泉、飲料水等に生息し、病院内では冷却塔、給湯設備、浴槽、シャワー、酸素吸入器等の水に生息します。一般的に菌が増殖に必要な温度は20〜50℃と言われており、死滅の温度は70℃以上と言われています。レジオネラ属菌は栄養源の有機物があるスライムやバイオフィルム(生物膜)等に生息し、他の細菌や藻類等から必要な栄養分を吸収して増殖します。
未然に防止するため、定期的な検査をしましょう!!
| << Prev | Next >> |
一覧に戻る









